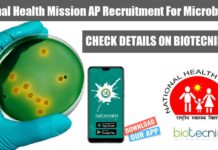
National Health Mission AP Recruitment – Applications Invited National Health Mission AP

Sun Pharma Biotech Executive Job Opening – Apply Online
Sun Pharma Biotech Executive Job Opening - Apply Online
Title: Executive Biotechnology
Date: Jul 10, 2024
Location: Tandalja - R&D
Company: Sun Pharmaceutical Industries Ltd
Key role:
Development of multiplex...
Biotecnika Times Newsletter 10.07.2024 – CSIR-CIMAP Student Internship Positions, Govt ILBS Hiring, Siemens Healthcare,...
CSIR-CIMAP Student Internship Positions With Monthly Fellowship For Life Sciences, Microbiology, Biotechnology, Biochem & Botany
CSIR-CIMAP offers student internship positions with a monthly fellowship for...
MSc Agricultural Sciences Jobs at CSIR-IMTECH – Apply Online
MSc Agricultural Sciences Jobs at CSIR-IMTECH - Apply Online
ROLLING ADVT. NO. 2024-07-03
Project Titled: “Microbial resource of authentic stains and related technical services: Ready-to-cater Indian...
DIAGEO Senior Executive Quality Assurance Job – Apply Now!
DIAGEO QA Job Vacancy For Biotech, food Tech, Biochem & Microbiology
Senior Executive - Quality Assurance
Locations: Nanded, India
Time type: Full time
Posted on: Posted Today
Job Requisition...
Cancer Research Project Assistant Recruitment at Govt ILBS Delhi! Apply Now
Govt ILBS Delhi Project Job Opening For Life Sciences, Apply Now
INTERVIEW FOR THE POST OF ‘PROJECT ASSISTANT’ UNDER PROJECT HBCRI
Project title: Hospital Based Cancer...
BSc Life Science Project Job at MACS-ARI Pune – Apply Online
BSc Life Science Project Job at MACS-ARI Pune - Apply Online
ONLINE INTERVIEW FOR TEMPORARY POSITION OF PROJECT TECHNICAL ASSISTANT (1 No.) IN THE NANOBIOSCIENCE...
Life Sciences & Biochem Apply at University of Calcutta For JRF in Cutting-Edge...
Calcutta University Biochemistry Research Vacancy - Life Sciences Apply
Advertisement for the post of Junior Research Fellow (JRF)
Department of Biochemistry, University of Calcutta
Applications are invited...
ICAR-IARI Genetics Division Research Fellow Job Openings For Life Sciences – Attend Walk-In-Interview
ICAR-IARI Genetics Division Research Fellow Job Openings For Life Sciences - Attend Walk-In-Interview
Division of Genetics
ICAR-Indian Agricultural Research Institute, New Delhi - 110012
Walk-In Interview
Applications are...
ICAR-IVRI Young Professional Job Opportunity For Life Sciences, Attend Walk-In-Interview
ICAR-IVRI Young Professional Job Opportunity For Life Sciences, Attend Walk-In-Interview
ICAR-Indian Veterinary Research Institute
Hebbal campus, Bengaluru-560024
Advertisement for Walk-in Interview for the Post of Young Professionals...
Medical Writing Job at Lilly – Life Science Apply Now!
Medical Writing Job at Lilly - Life Science Apply Now!
Medical Affairs – Medical Writing
Location: Bangalore, Karnataka, India
Category: Medical
Job Type: Full-Time Regular
Job Id: R-66732
Purpose:
Scientific data...
Siemens Healthcare Life Sciences Clinical Affairs Professional Opportunity – Apply Now
Siemens Healthcare Life Science Clinical Affairs Professional Opportunity - Apply Now
Clinical Affairs Professional
Bengaluru, Karnataka, India
Job Description
Job ID: 425920
Company: Siemens Healthcare Private Limited
Organization: Siemens Healthineers
Job...
Exciting QC Scientific Officer Job Opportunity at Panacea Biotec, Apply Now
QC Scientific Officer Job Opportunity at Panacea Biotec
Scientific Officer- QC (IMMUNOLOGY SECTION)
Baddi, Himachal Pradesh, India
About the job
Group Company: PANACEA BIOTEC LIMITED
Designation: SCIENTIFIC OFFICER (PBL.V.VFP.QC.I.SCIOFF)
Position...
CSIR-CIMAP Student Internship Positions With Monthly Fellowship For Life Sciences, Microbiology, Biotechnology, Biochem &...
CSIR-CIMAP Student Internship Positions With Monthly Fellowship For Life Sciences, Microbiology, Biotechnology, Biochem & Botany
Student Internship Positions
Student Internship positions (three number) are available at...
Biotecnika Times Newsletter 09.07.2024 – BIRAC High Paying Job, Arturo Falaschi Postdoctoral Fellowships, Hybrid...
BIRAC High Paying Job of Rs. 3 Lakh pm For Biotech, Life & Biological Sciences - Apply Online
BIRAC has announced vacancies for various biotechnology...
Unlock Your Future in Life Sciences: Arturo Falaschi Postdoctoral Fellowships Await!
Arturo Falaschi Postdoctoral Fellowships 2024 - Apply Online
Guidelines and Application Form
ICGEB offers competitive Postdoctoral Fellowships in Life Sciences to highly motivated scientists wishing to...